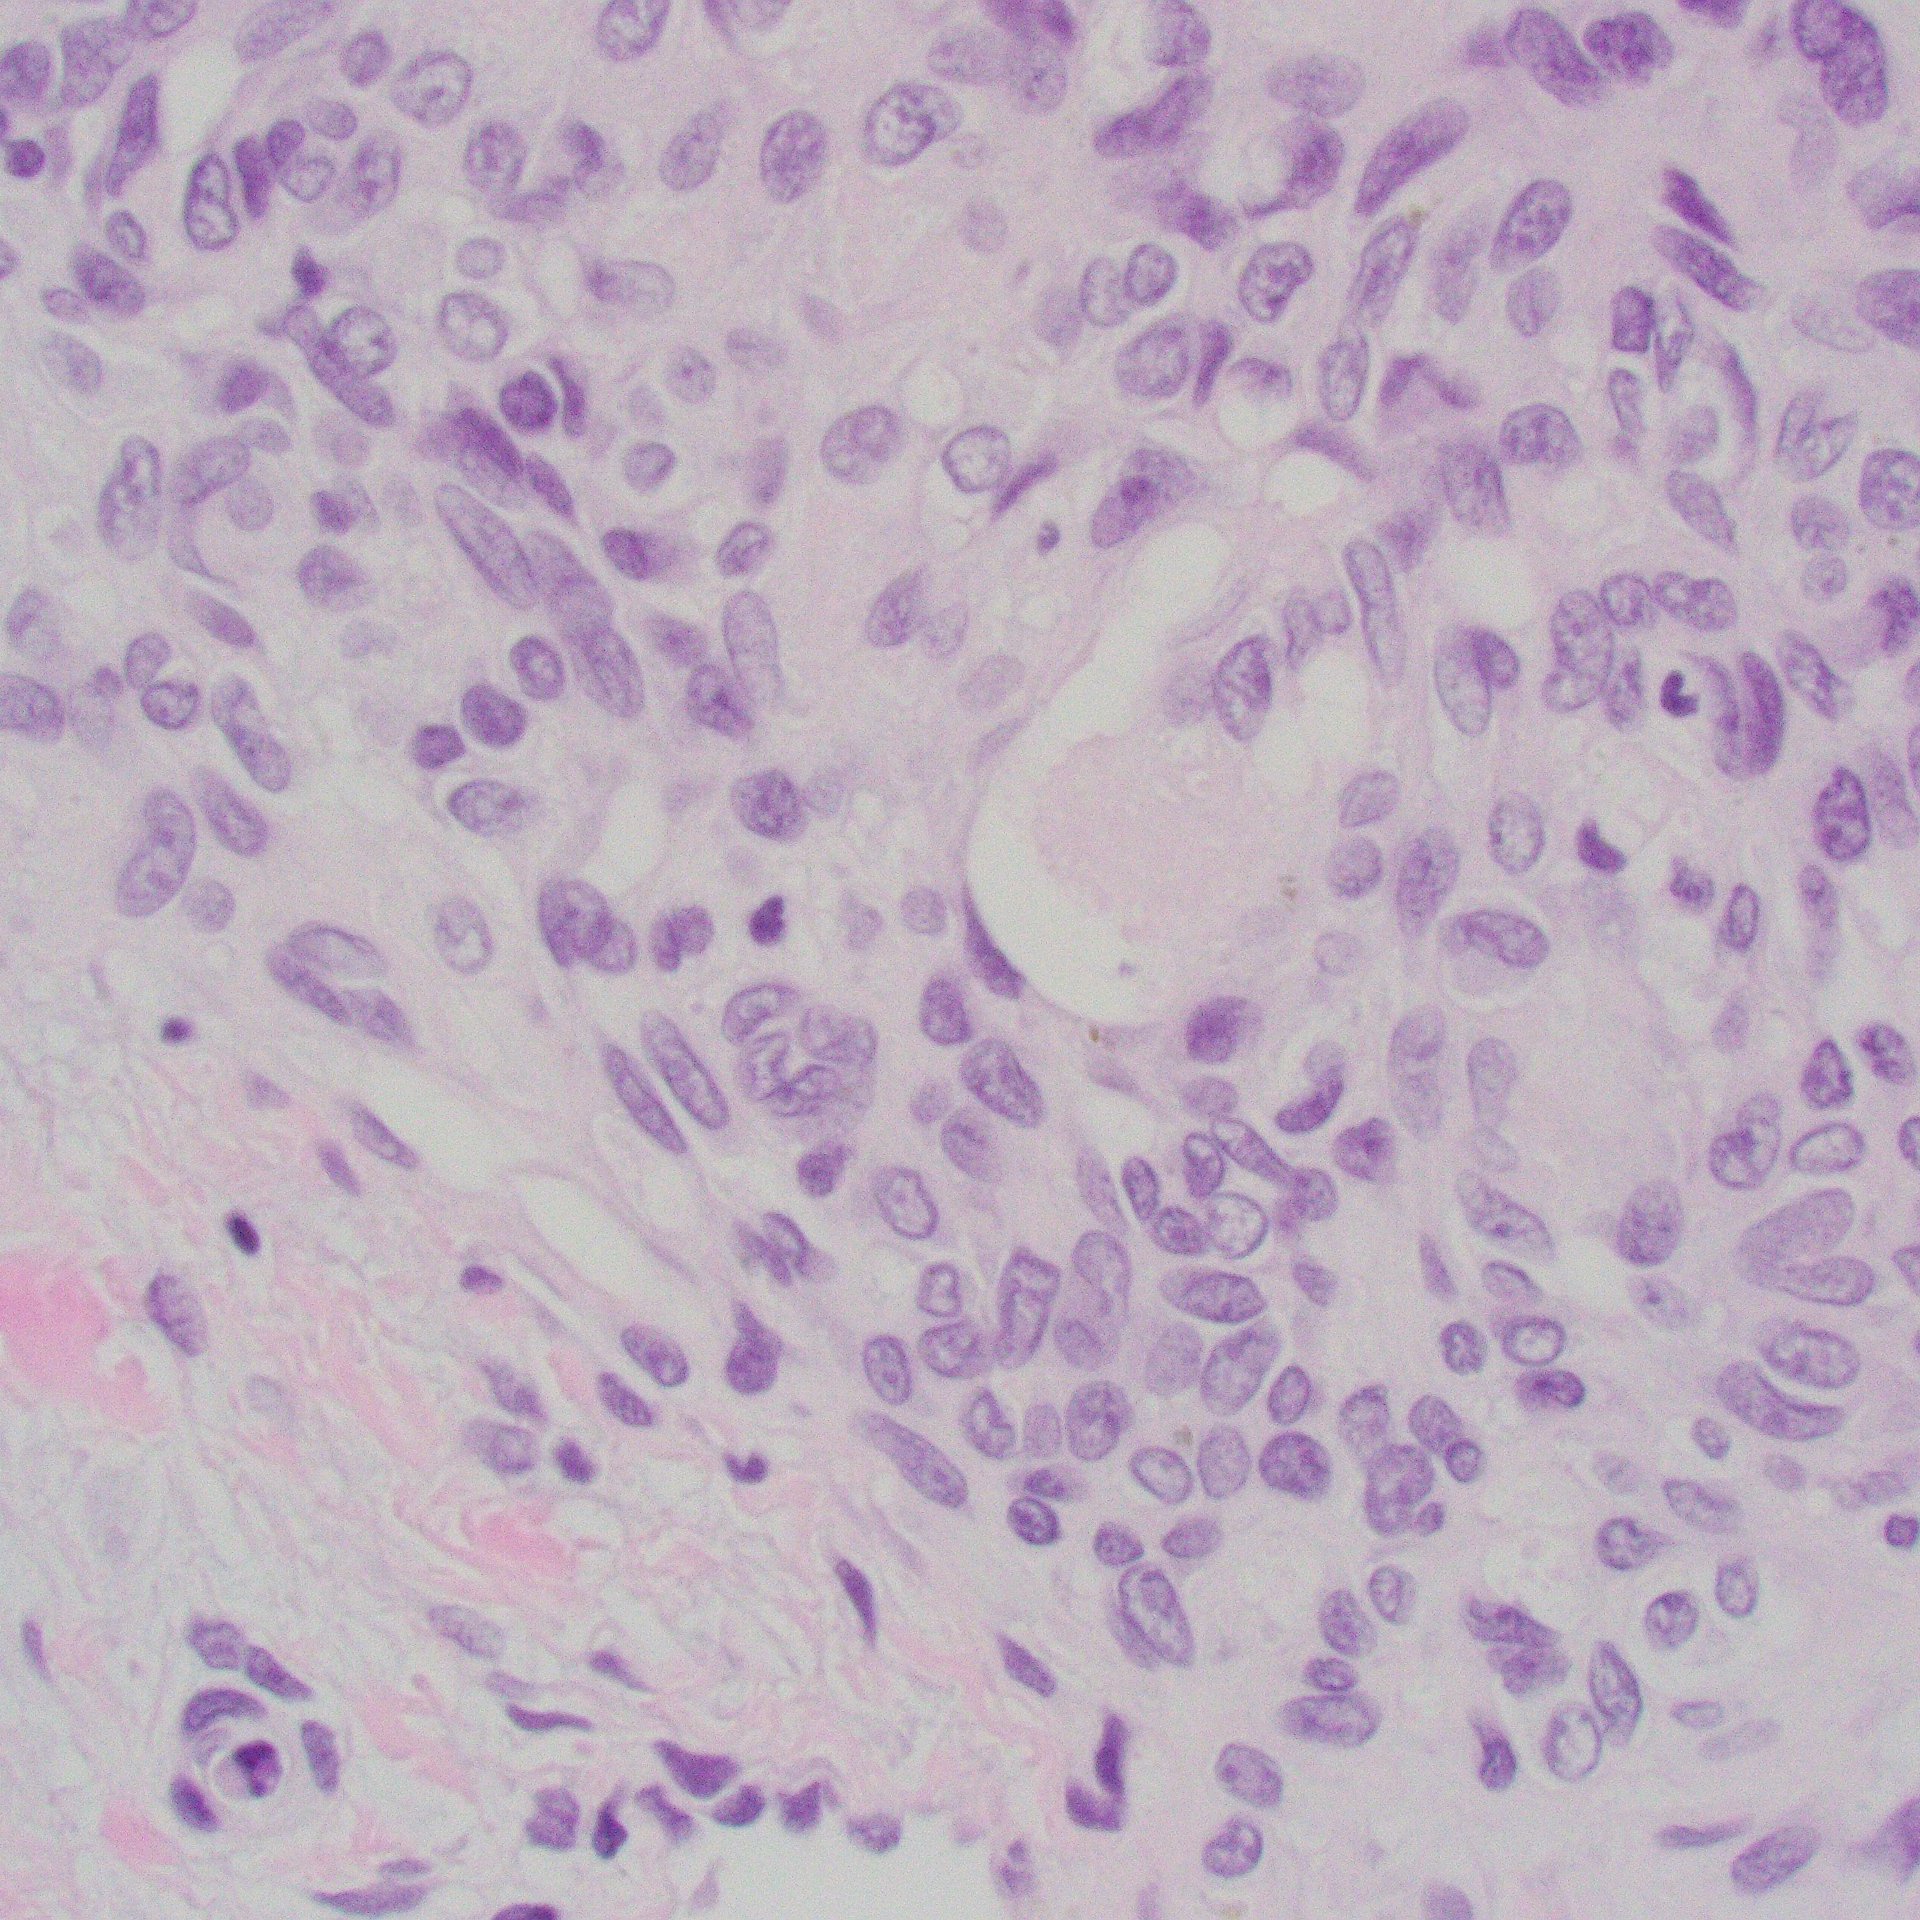

Pedi-Path Photo Atlas
Tap to enlarge photos. I will keep adding photos of important pediatric diseases, descriptions, references as much as possible.
Index
- Lung
- Tumor
- Soft tissue
- Skin/subcutanous tissue
- Vascular malformation/neoplasms
- Liver
- Cholestatic disease
- Microbiology
- Miscellaneous
Case 1: Infant with a cystic lesion in the lung
Images



Diagnosis
Congenital pulmonary airway malformation (CPAM Type 1)
- https://pubmed.ncbi.nlm.nih.gov/37334833/
- Type 1 (large cyst) CPAM
- Grossly cystic lung lesion
- Large cysts
- Cysts interspersed with relatively normal-appearing lung parenchyma
- Abnormal airways (bronchioles) anastomosing to alveolar spaces
- No mucocele (no bronchiolar obstruction)
- Type 2 (small cyst) CPAM
- Localized congenital airway (bronchiolar) obstruction.
- Small cysts : dilated small airways with mucus retention
- Localized congenital airway (bronchiolar) obstruction.
- Type 3 CPAM
- Solid/dense appearing lesion,
- Often with a lobulated appearance
- Distinct from the uninvolved lung parenchyma
- Type 4 is now PPB.
Case 2: Soft tissue lesion
Images



Diagnosis
Nodular Fasciitis
- Fibroblastic spindle cell proliferation
- Tissue culture-like growth pattern, bland nuclei
- Mitotic activity can be frequent (but not atypical)
- Variable cellularity
- Extracellular matrix ranges from myxoid to collagenous (older lesions may be more collagenous)
- Scattered lymphocytes, histiocytes, and osteoclast-type giant cells often present
- Areas of cystic degeneration may be identified
- Majority: MYH9::USP6 fusion; other fusion partners possible
Case 3: Two years-old, large neck mass
Images


Hypercellular, monotonous spindle cell tumor, scattered mitoses; this case had TPM3::NTRK1 fusion






IHC: CD34, S100, and panTRK are diffusely positive; this case had TPR::NTRK1 fusion
Diagnosis
NTRK1-associated Sarcoma
Case 4: Small round cell tumor
Images



IHC: CD99 (diffuse membranous), WT1 (patchy)
Diagnosis
CIC-rearranged sarcoma (CIC-DUX4 sarcoma)
- Monotonous, mild nuclear pleomorphism
- “Atypical” EwS
- Chromatin pattern more coarse and more prominent nucleoli than Ewing sarcoma (EwS)
- “Atypical” EwS
- Site:
- Deep soft tissue of the limbs or trunk > head and neck, retroperitoneum, and pelvis; 10% arise in viscera (kidney, gastrointestinal tract, and brain)
- CIC::DUX4 fusion
- Present in 95% of cases
- Either a t(4;19)(q35;q13) or a t(10;19)(q26;q13)
- Less common partner genes: FOXO4, LEUTX, NUTM1, and NUTM2A
- Present in 95% of cases
- IHC:
- Positive for CD99 (diffuse or patchy, membranous and/or cytoplasmic)
- WT-1 (nuclear with or without cytoplasmic in up to 95% of cases)
- ETV4
- Aggressive tumours, with frequent metastases and a poor outcome; EwS therapy less effective
Case 5: Infant with cholestasis
Images



Portal tracts show markedly reduced interlobular bile ducts.
Diagnosis
Paucity of Bile Duct by Alagille syndrome
- Histology
- Portal tracts are devoid of bile ducts;
- Ratio of bile ducts to portal tracts: <0.5 (normal: 0.9 to 1.8)
- Ductular proliferation: rare or milder than BA
- Giant cell transformation: can be seen, especially <1y
- Portal tracts are devoid of bile ducts;
- Alagille syndrome (MIM #118450)
- Clinical features
- Hepatic: chronic cholestasis (87-100%), jaundice (66-85%), cirrhosis (44-95%)
- Cardiac: murmur or cardiac anomalies (63-98%)
- Most common: peripheral pulmonic stenosis
- Others: tetralogy of Fallot, ductus arteriosus, septal defects, or coarctation of the aorta
- Vertebral: butterfly vertebrae (24-87%)
- Eyes:
- Most common: posterior embryotoxon (56-95%) – prominent Schwalbe line
- Others: optic disc abnormalities, hypopigmentation of peripheral retina, and pseudo and true papilledema
- Ears: hearing loss (40-60%)
- Facies: dysmorphic facies (78-95%)
- Broad nasal bridge
- Briangular facies (broad forehead and pointed chin)
- Deep-set eyes
- Renal: renal involvement (19-74%)
- Most common: renal dysplasia
- Short stature and/or failure to thrive
- Developmental delay (approxiately 10%)
- Likely due to malnutrition
- “Non-syndromic” paucity of interlobular bile ducts
- Apha-1 antitrypsin deficiency
- Cystic fibrosis
- Infections (TORCH, especially cytomegalovirus; syphilis)
- Mitochondrial disorders
- PFIC1 and PFIC2
- Arthrogryposis-renal dysfunction-cholestasis syndrome
Case 6: Localized lober overinflation, infant
Images





A lobe with dilated alveolar spaces; no disruption of alveolar septae
Diagnosis
Congenital Lobar Emphysema
- Also known as congenital alveolar overdistension, congenital lobar overinflation, and infantile lobar emphysema
- A developmental anomaly of the lower respiratory tract (1 in 20,000-30,000)
- Characterized by hyperinflation of one or more of the pulmonary lobes
- Compression of the remaining lung tissue
- Left upper lobe: most common (40-50%)
- Right middle, right upper, and lower lobes: 25-35, 20, and 2-10%, respectively.
- Multiple lobes: rare
- Usually are symptomatic in the neonatal period.
- 25-33% at birth, 50% by one month, and nearly all by 6 months of age
Case 7
Images





Pouch of skin internally lined by arachnoid tissue (EMA pos) and glial tissue (GFAP pos)
Diagnosis
Myelomeningocele
- A neural tube defect characterized by a cleft in the vertebral column
Case 8: Lung nodule, immunocompromised patient
Images



Necritzing granuloma, rare degenerated spherules identified (H&E and GMS-fungal stains)
Diagnosis
Coccidioidomycosis (lung)
- Necrotizing granulomatous inflammation
- Organisms are rare and difficult to find
- Often degenerated (like this case)
- Spherules
- Up to 100 μm in diameter
- Thick, eosinophilic wall
- Containing multiple basophilic or pale endospores (up to 5 μm)
Case 9: Bone lytic lesion
Images

Ill-defined, coalescing nodules of spindled endothelial cells forming elongated slit-like lumina containing erythrocytes and cytoplasmic vacuoles and pericytes. There are occasional platelet-rich microthrombi (left). Dilated crescentic lymphatics surround and intermingle with nodules, most prominently at peripheral margins.
Spindled endothelial cells are positive for CD31, CD34, and ERG, as well as the lymphatic markers, podoplanin, LYVE1, and PROX1
Diagnosis
Kaposiform haemangioendothelioma (KHE)
- A rare, vascular neoplasm usually presenting in children
- GNA14 c.614A>T (p.Gln205Leu) mutation in some cases
- Site:
- Usually in deep soft tissue (extremities, head and neck, trunk, and retroperitoneum; less commonly, the mediastinum, spleen, bone, and testis)
- Can be multifocal, especially in bone
- Tufted angioma (TA): more superficial lesion, otherwise essentially identical to KHE
- Characterized by lobular infiltrates of capillaries and spindled endothelial cells associated with lymphatic vessels.
- KHE and TA cause platelet-trapping syndrome Kasabach–Merritt phenomenon (platelet-trapping syndrome)
- Prognosis:
- Untreated lesions may partially undergo fibrosis and regress – not fully regress
- Often recur
- Large lesions: high mortality due to thrombocytopenia or tumour infiltration
- Medical therapy: first line
- e.g. vincristine, steroids, mTOR inhibitors (sirolimus etc.)
- No distant metastases have been reported.
- Lymph node involvement is rarely seen.
- This may represent multifocal lymphatic chain involvement rather than true metastasis.
Case 10: Subcutaneous nodules
Images





Demarcated dense intradermal infiltrate of foamy histiocytes extending to the subcutis in large lesions; scattered Touton giant cells are characteristic (third photos). The histiocytes are positive for CD68 (forth photo) and Factor XIIIa (fifth photo, weak in this case)
Diagnosis
Juvenile xanthogranuloma (JXG)
- Benign proliferative non-Langerhans cell histiocytic proliferation
- Occurs predominantly in young children
- Clinically, a solitary red-brown, yellowish papule or nodule, most often on the head and neck area; systemic JXG can involve any organ system
- Histologically characterized by the presence of histiocytes, foam cells and Touton giant cells
- Generally a benign course with spontaneous resolution over a period of a few years
